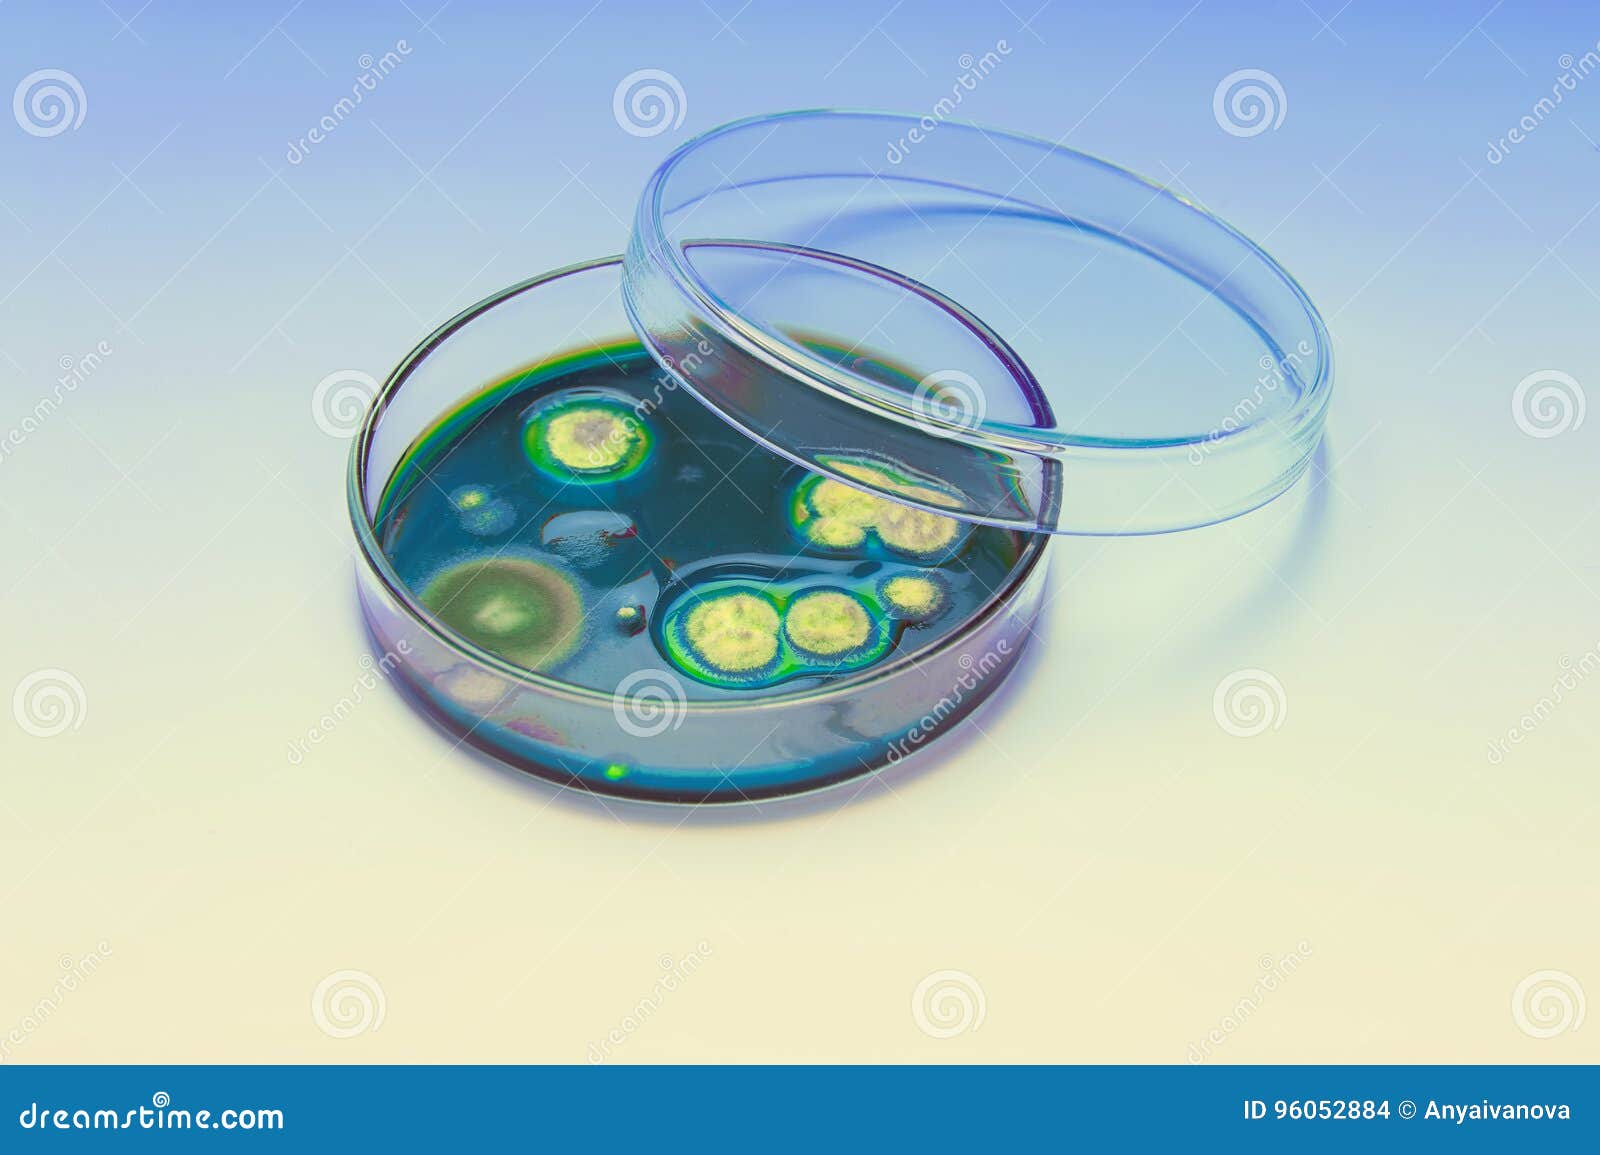

Чашка петри назначение
Газы класс опасных грузов
Фото V 40
Акулова Ангелина Владимировна Самара Фото
Он игра майнкрафт
Нет вариантов есть варианты
Усилитель 100у 021
Слова из 5ти вторая о третья с
Никалэнд ул труда 183 корп 1 фото
Хорошая не значит любимая
5 музыкальных оркестров
Стрелка синего цвета
Погода в рагулях ставропольский
Rise o
Чашка петри назначение 111 фото